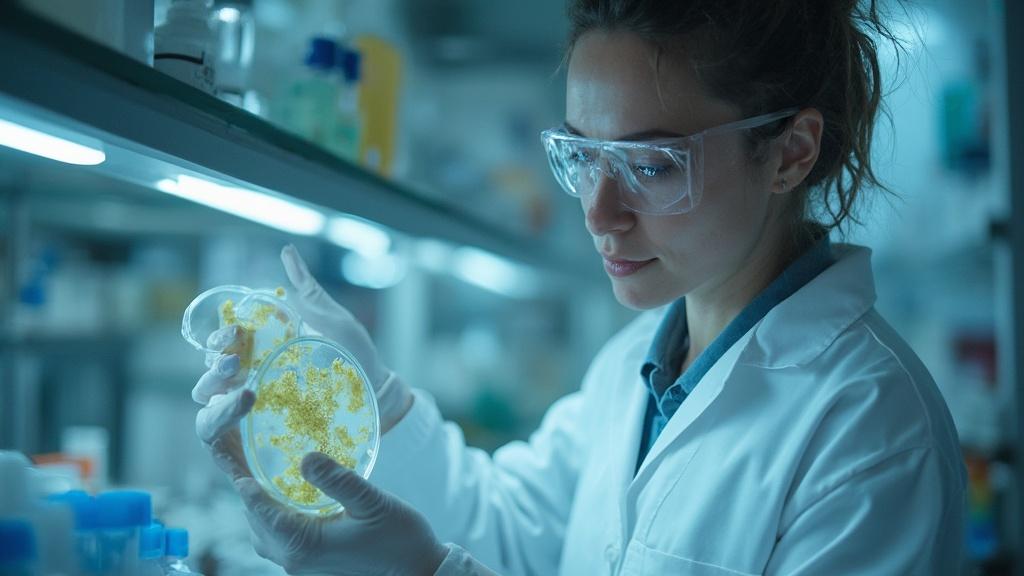

1. 발효 식품 생산의 환경적 효율성

환경에 대한 책임은 생산과 소비의 모든 과정에서 중요하며, 발효 식품은 이러한 책임을 다하기 위한 탁월한 선택입니다. 발효는 미생물을 이용해 식품을 발효시키는 과정으로, 자원 활용을 극대화하고 에너지 소비를 줄일 수 있는 생산 기술을 제공합니다.
KAIST 이상엽 교수 연구팀의 분석에 따르면, 발효 식품의 생산은 기존 농축산물 생산 대비 에너지 소모가 현저히 낮습니다. 발효 기술은 비식용 원료를 이용해 온실가스 배출과 폐기물을 줄이는 데 중대한 역할을 합니다. 이는 기후 변화 대응에 있어 큰 가능성을 보여주며, 환경적 지속 가능성을 실현하는 데 핵심적입니다.
또한, 발효 과정은 고도화된 온도 조절 기술 없이도 이루어질 수 있어 자연적이고 에너지 절약적인 생산 환경을 제공합니다. 예를 들어, 소위 "자연 발효" 방식은 기계적 개입을 줄여 생산 과정에서 환경적 부담을 최소화합니다. 이러한 점에서 발효 식품은 식품 기술 영역에서 혁신적이며 동시에 친환경적 대안을 제시합니다.
출처 : 연구 미래 식량인 미생물 식품 생산 전략 밝혀 가파른 인구 증가에 대응 / KAIST
2. 발효 식품 소비와 환경 보존: 선택과 보관 방법

발효 식품을 소비할 때 우리가 어떤 선택을 하느냐에 따라 환경에 미치는 영향을 크게 줄일 수 있습니다. 발효 식품의 보관은 그 자체로 친환경적이며, 음식물 쓰레기를 줄이는 핵심 단계가 됩니다.
먼저, 발효 식품은 특히 유리 용기나 재활용 가능한 소재를 이용해 보관하는 것이 좋습니다. 이는 “2025년도 고부가가치식품기술개발사업 추진계획”에서 제안된 농산물 부산물의 업사이클링 사례와도 같은 맥락으로, 환경 보호에 기여할 수 있습니다. 유리 용기는 반복 사용이 가능하며, 유해성 논란이 적어 안전한 선택입니다.
또한, 발효 식품은 다양한 레시피로 응용될 수 있어 음식물 낭비를 줄이는 데도 기여합니다. 가령 김치, 요구르트, 된장은 한 번 만들어두면 다양한 요리에 활용할 수 있으며, 필요 이상으로 식재료를 구입하지 않아도 됩니다. 이러한 실천은 경제적이면서 환경적으로도 유익합니다. 따라서 발효 식품 소비는 단순한 선택을 넘어서 환경 보존을 위한 효과적인 방법이 됩니다.
출처 : 2025년도 고부가가치식품기술개발사업 시행계획 공고 / 중소기업청
3. 음식물 폐기물을 줄이는 발효 식품의 마지막 단계

발효 식품이 생산과 소비 단계에서 환경을 보호한다면, 폐기 단계에서도 이는 친환경적 가능성을 열어줍니다. 발효 식품의 생분해성은 자연에서 자원을 순환시키는 데 매우 적합합니다.
예를 들어, 발효된 식품의 폐기물을 유기농 비료로 사용하는 컴포스트화 기술은 지속 가능한 자원 관리 방식을 보여줍니다. 실제로 감귤박이나 버섯배지를 활용한 업사이클링 사례처럼, 발효 식품의 남은 부산물도 같은 방식으로 활용될 수 있습니다. 이는 폐기 과정에서 발생하는 온실가스를 대폭 줄이는 동시에 새로운 자원으로 변환하는 기회를 제공합니다.
이처럼 발효 식품은 폐기 과정마저도 환경적으로 배려한 설계를 가능하게 합니다. 음식물 쓰레기가 아닌 **"순환 가능한 자원"**으로 개념을 바꾸는 발상의 전환이 곧 지속 가능성을 향한 큰 발걸음이 될 것입니다.
4. 환경적 지속 가능성을 고려한 발효 식품의 미래
발효 식품은 단순히 우리의 식탁을 채우는 것을 넘어서, 급변하는 기후 변화 속에서 미래 식량 자원의 대안으로 주목받고 있습니다. 이는 발효 식품이 저에너지 소비와 비식용 원료 활용이라는 점에서 환경 부담을 줄이고 자원을 더욱 효율적으로 사용할 수 있기 때문입니다.
실제로 발효 과정은 플라스틱 대체 소재나 식물성 대체 식품 개발에도 적용 가능하며, 미래 산업 전반에 걸쳐 혁신적인 변화를 가져올 잠재력을 지니고 있습니다. KAIST 연구진은 발효 기술을 활용해 식용 계란 대체품 개발까지 성공하며 그 유용성을 증명했습니다. 이러한 기술적 진보는 발효 식품이 단순히 지속 가능성을 넘어 필수 자원이 될 수 있음을 보여줍니다.
앞으로 우리는 발효 식품의 가치를 단순히 한정된 영역에서 해석하지 않고, 건강, 환경, 그리고 전 세계적인 자원 관리라는 더 큰 맥락에서 바라봐야 합니다. 이러한 지속 가능한 여정은 개인이 일상에서 발효 식품을 선택하고 실천으로 옮기는 작은 변화에서 시작될 수 있습니다.